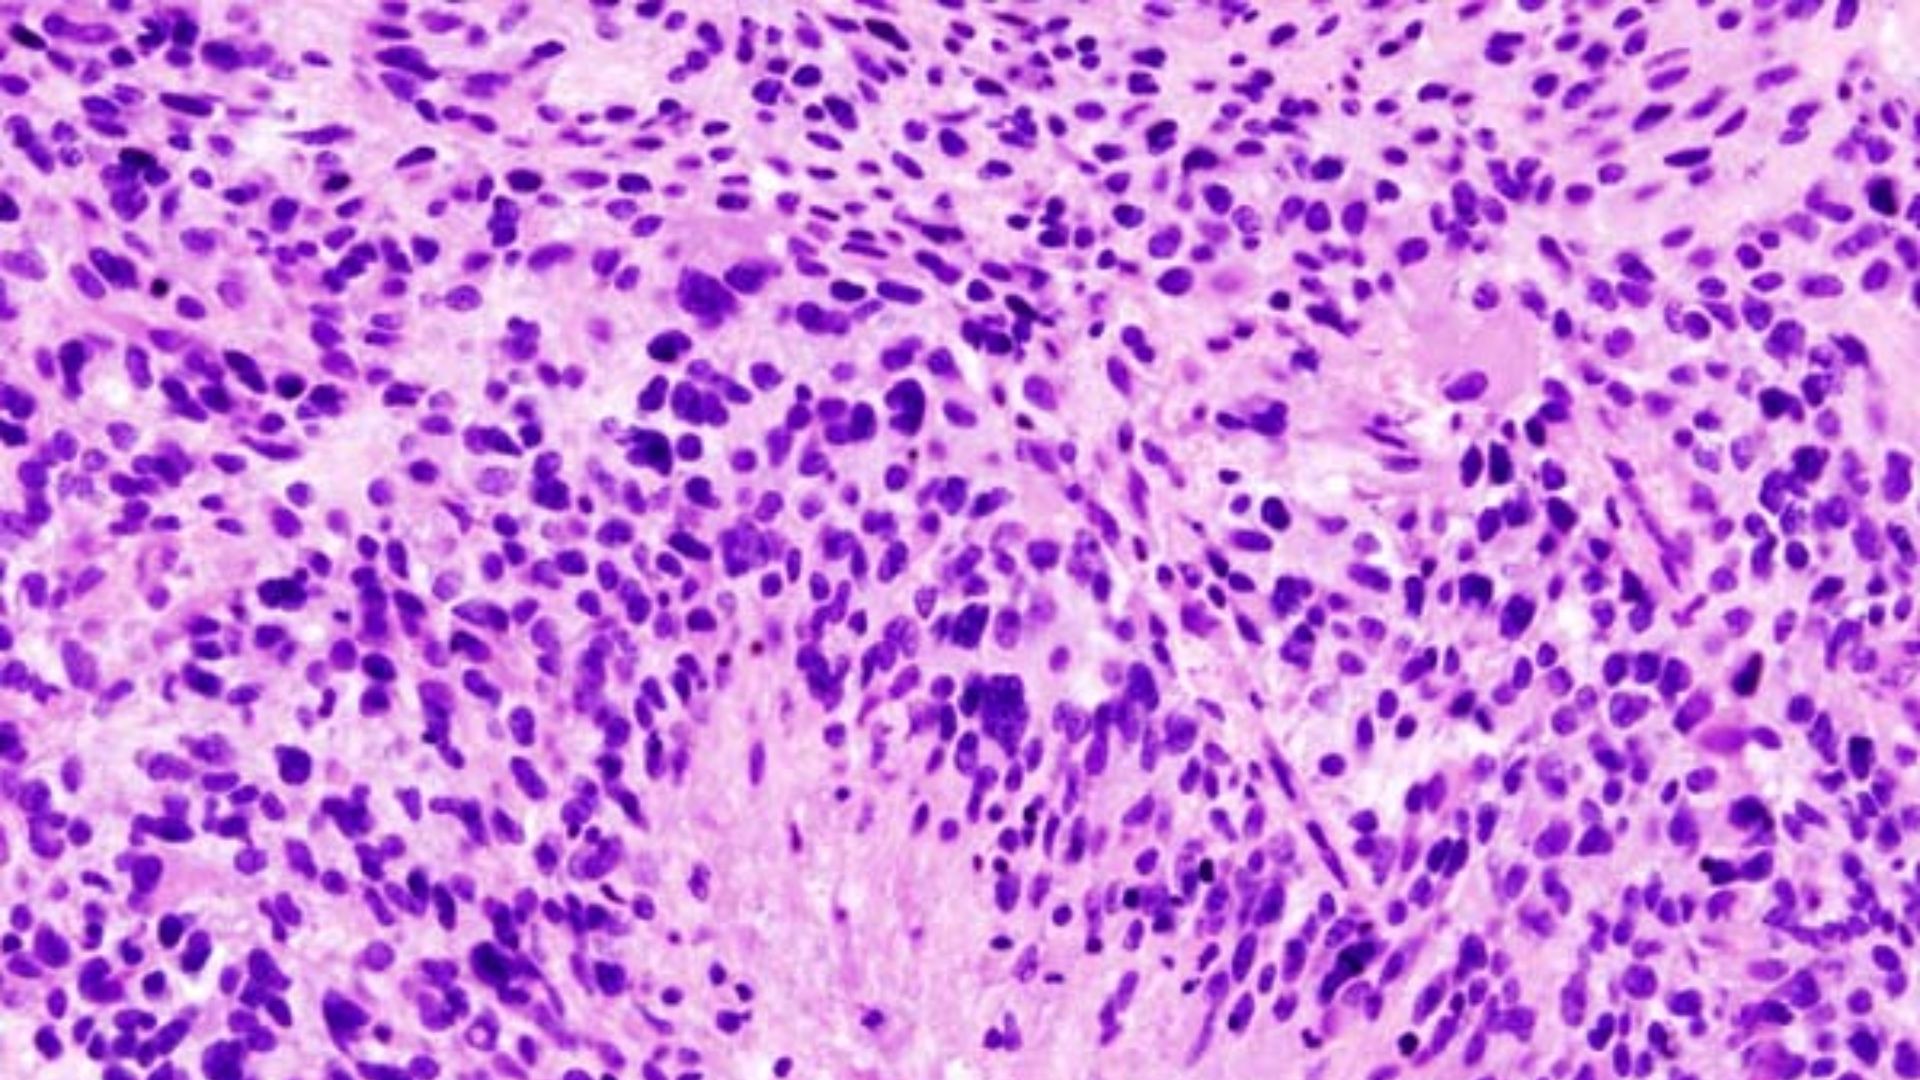
File:Glioblastoma (1).jpg

At the Frontier of Medicine
Medical science has accomplished things that would've seemed like magic a century ago. Transplanting organs, editing genes, and turning AIDS from a death sentence into a manageable condition is fairly customary in our modern medical age. Yet for all these triumphs, there remain illnesses that mock our best efforts. Some of these diseases kill quickly, whereas others slowly unravel everything that makes a person themselves. As research continues, the hope remains that what's untreatable today might not be tomorrow. Here are ten illnesses we can’t yet stop and ten breakthroughs that could change everything.
1. Prion Diseases
Prion diseases progress rapidly once symptoms appear, and no therapy exists beyond palliative care. These aren’t caused by viruses or bacteria. Instead, they’re triggered by misfolded proteins that force other proteins to misfold in a catastrophic chain reaction.
2. Rabies
Once clinical symptoms appear, rabies is almost universally fatal. The Milwaukee Protocol—inducing a coma and using aggressive antiviral treatment—has saved a handful of people, maybe fifteen total, but with severe neurological damage.
3. Primary Amoebic Meningoencephalitis
Naegleria fowleri, also known as the brain-eating amoeba, enters through the nose, usually when someone's swimming or diving, then migrates to the brain where it causes devastating inflammation. Fewer than ten people out of over 150 cases in the US have survived, and that's with aggressive treatment started immediately.
 The New York Public Library on Unsplash
The New York Public Library on Unsplash
4. Advanced Pancreatic Cancer
Fewer than 13 percent of pancreatic cancer patients survive five years after diagnosis. The pancreas sits deep in the abdomen, surrounded by other organs, making early detection nearly impossible. Most people don't have symptoms until the cancer has already spread.
5. Glioblastoma
This aggressive brain cancer has a median survival of 12-15 months even with surgery, radiation, and chemotherapy. It infiltrates brain tissue in a manner that is impossible to remove without destroying healthy brain function. Tumor cells hide behind the blood-brain barrier where many drugs can't reach them.
No machine-readable author provided. KGH assumed (based on copyright claims). on Wikimedia
No machine-readable author provided. KGH assumed (based on copyright claims). on Wikimedia
6. Advanced ALS
ALS progressively destroys motor neurons, the nerve cells controlling voluntary muscles. Eventually, you can't walk, speak, swallow, or breathe. Cognitive function usually stays intact, leaving patients fully aware as their bodies betray them. Most die within three to five years from respiratory failure.
7. Multi-Drug Resistant Tuberculosis
While regular tuberculosis is curable, extensively drug-resistant TB strains require two years of multiple antibiotics with tough side effects, and success rates pale at around 50%. The bacteria develop resistance faster than new drugs appear.
 Unknown authorUnknown author on Wikimedia
Unknown authorUnknown author on Wikimedia
8. Advanced Alzheimer's Disease
The plaques and tangles characteristic of Alzheimer's destroy brain cells and their connections. Memory loss and cognitive decline become irreversible in moderate to severe stages. New drugs may slightly slow early-stage progression, but nothing reverses later damage.
9. Hantavirus Pulmonary Syndrome
Transmitted through contact with rodent droppings or urine, this virus attacks the lungs and heart with a fatality rate near 38%. There is no specific antiviral treatment, only supportive care.
10. NDM-CRE Drug-Resistant Infections
New Delhi metallo-beta-lactamase carbapenem-resistant Enterobacterales (NDM-CRE) represent a sharp rise in untreatable bacterial infections. These superbugs resist nearly all standard antibiotics, threatening higher infection and death rates in hospitals worldwide. Treatment options remain severely limited despite aggressive infection control measures.
And now, here are ten medical breakthroughs making their way through the pipeline.
1. Lenacapavir for HIV Prevention
Injectable lenacapavir blocks nearly all HIV transmission when administered twice yearly. Clinical trials showed near-perfect efficacy as pre-exposure prophylaxis, replacing daily pills with biannual injections.
2. Custom CRISPR Gene Therapy
In 2025, CRISPR with lipid nanoparticles corrected a genetic mutation in a child's liver, dramatically improving their health. This custom-designed therapy for individual mutations opens doors for millions with rare genetic diseases.
3. Xanomeline-Trospium for Schizophrenia
FDA-approved in 2024, this new schizophrenia medication targets muscarinic receptors instead of dopamine, avoiding many side effects of older antipsychotics and improving patient tolerance.
4. GLP-1 Drugs Beyond Diabetes
Originally formulated for diabetes, drugs like semaglutide and tirzepatide promote weight loss, reduce cardiovascular risk, improve kidney function, and may help with sleep apnea. They reframe metabolic disease treatment biologically rather than as a willpower issue.
5. Early Pancreatic Cancer Detection
2025 breakthroughs in blood biomarkers could identify pancreatic cancer early. This early detection could potentially raise five-year survival rates from under 13% to around 44% by detecting surgically treatable stages.
 National Cancer Institute on Unsplash
National Cancer Institute on Unsplash
6. Omalizumab for Multiple Food Allergies
FDA-approved for food allergies in 2024, this drug initially used for asthma reduces life-threatening allergic reactions to peanuts and others after months of treatment, offering transformative protection to vulnerable families.
7. Blood Test for Alzheimer's Detection
The PrecivityAD2 blood test developed in 2024 diagnoses Alzheimer's with 90% accuracy, enabling earlier intervention as new drugs work mainly in early disease stages. It’s one of several blood-based diagnostics that are rapidly replacing invasive spinal taps and costly brain scans.
8. Porcine Xenotransplantation
Genetically modified pig organs successfully transplanted into humans in 2024 could drastically reduce the organ transplant waiting list of over 100,000 Americans by providing an abundant supply. If the approach proves safe long-term, it could transform transplantation from a desperate shortage to a predictable medical service.
9. CAR-T Immunotherapy for Blood Cancers
In 2025, seven new FDA-approved CAR-T cell therapies advanced treatment for leukemia and lymphoma, achieving remission in up to 80% of some cases by engineering patients' immune cells to target cancer. These innovations expand options for advanced cancers previously resistant to standard care.
 National Cancer Institute on Unsplash
National Cancer Institute on Unsplash
10. Bionic Retinal Implants
New-generation retinal implants use tiny electrodes to convert visual information into electrical signals the eye can interpret. In recent studies, blind patients were able to perceive shapes, doorways, and movement. This is an enormous leap beyond earlier devices that could only provide pixelated images. The next versions aim for full color and higher resolution.
KEEP ON READING























